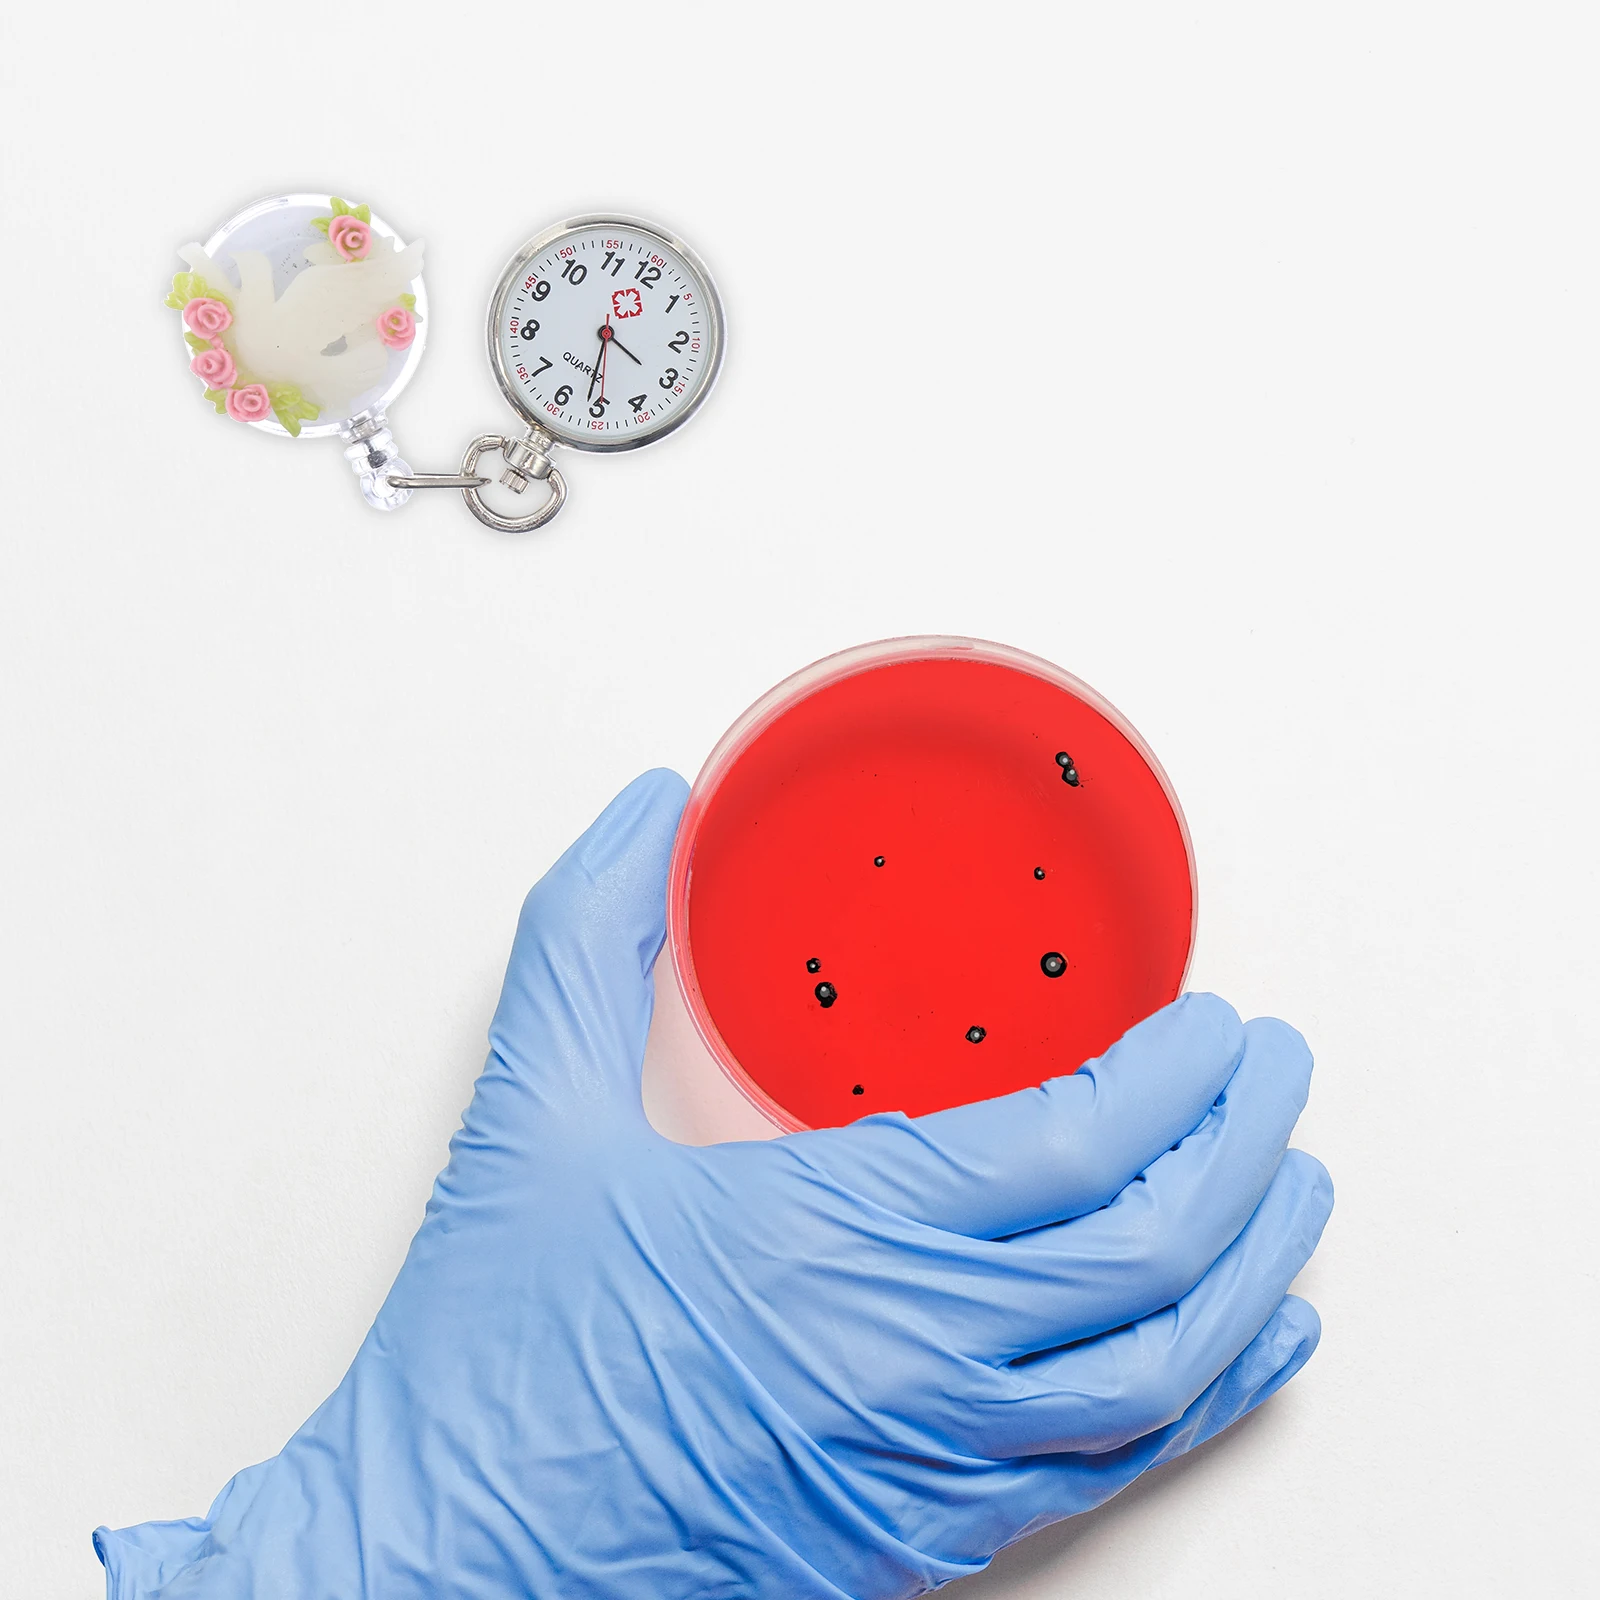

Подставка для дверного звонка со встроенным винтом и защитой от кражи
Price history chart & currency exchange rate
Customers also viewed

$1.61
6 Pcs Clear Glasses Storage Box Durable Portable Eyeglasses Case for Sunglasses Anti-pressure Outdoor Practical Pouch
aliexpress.com
$11.26
3 Minutes Firm Eye Cream Lifting Tighten Alleviate Eye Bags Dark Circles Moisturize Peptide Brighten Skin Eye Care Eye Cream
aliexpress.com
$61.33
Square Toe Super High Heels Women's Slippers Fashion Solid Color Half Head Slipper 10Cm Thick Heel Sandals Summer Female Shoes
aliexpress.com
$414.59
Роскошный стильный туалетный столик для спальни современный европейский туалетный столик для девушек зеркало для макияжа подставки для макияжа мебель для дома
aliexpress.com
$99.90
Автомобильный Компрессор кондиционера для Харрисона V5 SY Rexton SSANGYONG 6651305011 6611304415 6611304915 6PK 12 В
aliexpress.com
$26.65
Модный Новый Женский Повседневный трикотажный комплект из двух предметов, элегантный шикарный свитер в рубчик, топы, плиссированная мини-юбка, костюм, женская одежда
aliexpress.com
$7.12
Belle Delphine Dress Socks Mens Womens Warm Fashion Novelty British Internet Celebrity Crew Socks
aliexpress.com
$15.48
Tin Can Metal Cans Kitchen Round Steering Pails Buckets Power Containers Oil Bucket Reservoir Empty Canisters Storage Lid Set
aliexpress.com
$31.58
Электронный Термостат для Chery Tiggo 7 8 Tiggo7 Tiggo8 Exeed TX LX VX Jetour F4J16
aliexpress.com
$310.00
Fit for Toyota Land Cruiser LC76 LED Tail Light 1984 - 2020 high quality tail light assembly LED taillight easy installation
aliexpress.com
$18.27
1pc Black Replacement Diagnostic Wires 1137658-00-a Fits Model 3/Y Toolboxes Tools Auto Parts
aliexpress.com
$366.03
Can Be Used For Outdoor Live Real-time Video Streaming Services RTSP TO RTMP RTMPS HLS 4G Network Video Encoder
aliexpress.com
$16.80
Parking number plate, digital display, zero hour parking, mobile phone, phone number plate, electronic display, etc
aliexpress.com
$19.88
Hellstar T Shirts Men Women Couples Simple Fashion Black Top Tee High Quality Streetwear Harajuku HELLSTAR T-shirt
aliexpress.com
$15.41
Обмотка переднего лобового стекла для Toyota Corolla 2014-2019, угловая отделка лобового стекла, Боковая Отделка
aliexpress.com
$25.14
Car Carbon Fiber Front Side Bumper Trim for Chevrolet Corvette C7 2014-2018 Bumper Lip Corner Splitter Strip
aliexpress.com
$23.65
1Z0959858B For SKODA Fabia Octavia Super B For Yeti DRIVER Power Window Switch Button 1Z0 959 858B 1ZD959856
aliexpress.com
$18.11
Summer Women Camo Print Cargo Pocket Short Sleeve Crop Top & Mini Skirt Sets Slim Fit Casual 2 piece Sets Outfits Streetwear
aliexpress.com
$17.97
Woods Lamp For Skin Analyzer Machine Ultraviolet Lamp Uv Skin Examination Beauty Test Facial Magnifying Analysis Vitiligo Lamp
aliexpress.com
$21.05
25pcs Christmas Theme Portable Candy Box Foldable Shape Snowman Pattern Gift Bag for Christmas Party Packaging Cookie Wrapping
aliexpress.com
$12.93
Matisse, женское одеяло для сна, пушистое одеяло, диванное одеяло, мягкое одеяло, большое одеяло
aliexpress.ru
$22.99
Heated Gloves Waterproof Non-slip Touch Screen Rechargeable Battery Powered Electric Heated Hand Warmer For Skiing Cycling
lightinthebox.com
$18.43
Enfants filles robe de noël bonhomme de neige tenue décontractée au-dessus du genou robe cadeaux de noël ras du cou à manches longues adorable robe 2-13 ans hiver rouge
lightinthebox.com
$19.12
BENYAR 5112 Special design waterproof stylish leather wrist watches for men, As picture
alibaba.com
$16.84
Женская рубашка с лацканами и принтом зебры, Осенний Модный женский Кардиган с длинным рукавом, Яркий Женский Топ с длинным рукавом
aliexpress.ru
$1.50
Для Garmin Forerunner 235 ремешок с силиконовым браслетом, браслет для наручных часов Garmin Forerunner 220/230/235/620/630/735XT/235Lite аксессуар Correa
aliexpress.ru
$16.25
Hunting Accessories Gun Holster For Glock 17 19 22 23 31 32 Airsoft Pistol Leg Holster Combat Gun Case Thigh Gun Bag, Black, tan
alibaba.com
$2.00
2020 Massage Tools Amazon hot mini eye massager massage stone in green aventurine roller supplier
alibaba.com
$35.00
2021 Polo shirt Mens Breathable Short Sleeve Polo Shirts Man Casual Slim Turn Down Collar Male Polos tops customized
aliexpress.com
$23.18
12 Rolls Carton Sealing Clear Packing Tape Box 2.7 mil 1.8" x 60 Yards Seal Tapes Express packing Tape US Free Shipping
aliexpress.com
$24.46
Aluminum alloy manufacturer Multifunctional Sausage Meat Grinder Sausage Filling Household Table Kitchen Tools
aliexpress.com
$1,007.14
*American rural solid wood wine cabinet, simple and beautiful style simple small wine cabinet
aliexpress.com
$26.80
Knife Sharpener Set Sharpening Stone Grit Tool for Cutters Scissors Kitchen Supplies Desktop Chisel Honing
aliexpress.com